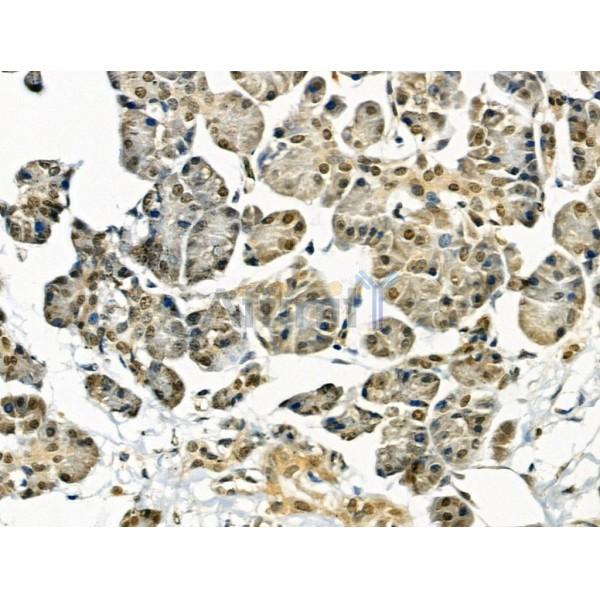
AKAP8 Antibody - AF0333 at 1/100 staining Human pancreatic cancer and adjacent nomal tissues by IHC-P.

AKAP8 Antibody - #AF0333
| Product: | AKAP8 Antibody |
| Catalog: | AF0333 |
| Description: | Rabbit polyclonal antibody to AKAP8 |
| Application: | WB IHC IF/ICC |
| Cited expt.: | WB |
| Reactivity: | Human, Mouse, Rat |
| Prediction: | Bovine, Horse, Sheep, Dog |
| Mol.Wt.: | 76kDa(Observed); 76kD(Calculated). |
| Uniprot: | O43823 |
| RRID: | AB_2833493 |
Related Downloads
Protocols
Product Info
*The optimal dilutions should be determined by the end user. For optimal experimental results, antibody reuse is not recommended.
*Tips:
WB: For western blot detection of denatured protein samples. IHC: For immunohistochemical detection of paraffin sections (IHC-p) or frozen sections (IHC-f) of tissue samples. IF/ICC: For immunofluorescence detection of cell samples. ELISA(peptide): For ELISA detection of antigenic peptide.
Cite Format: Affinity Biosciences Cat# AF0333, RRID:AB_2833493.
Fold/Unfold
A kinase (PRKA) anchor protein 8; A kinase anchor protein 8; A kinase anchor protein 95; A kinase anchor protein 95 kDa; A kinase anchor protein 95kDa; A-kinase anchor protein 8; A-kinase anchor protein 95 kDa; AKAP 8; AKAP 95; AKAP-8; AKAP-95; Akap8; AKAP8_HUMAN; AKAP95; DKFZp586B1222;
Immunogens
A synthesized peptide derived from human AKAP8, corresponding to a region within the internal amino acids.
Highly expressed in heart, liver, skeletal muscle, kidney and pancreas. Expressed in mature dendritic cells.
- O43823 AKAP8_HUMAN:
- Protein BLAST With
- NCBI/
- ExPASy/
- Uniprot
MDQGYGGYGAWSAGPANTQGAYGTGVASWQGYENYNYYGAQNTSVTTGATYSYGPASWEAAKANDGGLAAGAPAMHMASYGPEPCTDNSDSLIAKINQRLDMMSKEGGRGGSGGGGEGIQDRESSFRFQPFESYDSRPCLPEHNPYRPSYSYDYEFDLGSDRNGSFGGQYSECRDPARERGSLDGFMRGRGQGRFQDRSNPGTFMRSDPFVPPAASSEPLSTPWNELNYVGGRGLGGPSPSRPPPSLFSQSMAPDYGVMGMQGAGGYDSTMPYGCGRSQPRMRDRDRPKRRGFDRFGPDGTGRKRKQFQLYEEPDTKLARVDSEGDFSENDDAAGDFRSGDEEFKGEDELCDSGRQRGEKEDEDEDVKKRREKQRRRDRTRDRAADRIQFACSVCKFRSFDDEEIQKHLQSKFHKETLRFISTKLPDKTVEFLQEYIVNRNKKIEKRRQELMEKETAKPKPDPFKGIGQEHFFKKIEAAHCLACDMLIPAQPQLLQRHLHSVDHNHNRRLAAEQFKKTSLHVAKSVLNNRHIVKMLEKYLKGEDPFTSETVDPEMEGDDNLGGEDKKETPEEVAADVLAEVITAAVRAVDGEGAPAPESSGEPAEDEGPTDTAEAGSDPQAEQLLEEQVPCGTAHEKGVPKARSEAAEAGNGAETMAAEAESAQTRVAPAPAAADAEVEQTDAESKDAVPTE
Predictions
Score>80(red) has high confidence and is suggested to be used for WB detection. *The prediction model is mainly based on the alignment of immunogen sequences, the results are for reference only, not as the basis of quality assurance.
High(score>80) Medium(80>score>50) Low(score<50) No confidence
Research Backgrounds
Anchoring protein that mediates the subcellular compartmentation of cAMP-dependent protein kinase (PKA type II). Acts as an anchor for a PKA-signaling complex onto mitotic chromosomes, which is required for maintenance of chromosomes in a condensed form throughout mitosis. Recruits condensin complex subunit NCAPD2 to chromosomes required for chromatin condensation; the function appears to be independent from PKA-anchoring. May help to deliver cyclin D/E to CDK4 to facilitate cell cycle progression. Required for cell cycle G2/M transition and histone deacetylation during mitosis. In mitotic cells recruits HDAC3 to the vicinity of chromatin leading to deacetylation and subsequent phosphorylation at 'Ser-10' of histone H3; in this function may act redundantly with AKAP8L. Involved in nuclear retention of RPS6KA1 upon ERK activation thus inducing cell proliferation. May be involved in regulation of DNA replication by acting as scaffold for MCM2. Enhances HMT activity of the KMT2 family MLL4/WBP7 complex and is involved in transcriptional regulation. In a teratocarcinoma cell line is involved in retinoic acid-mediated induction of developmental genes implicating H3 'Lys-4' methylation. May be involved in recruitment of active CASP3 to the nucleus in apoptotic cells. May act as a carrier protein of GJA1 for its transport to the nucleus. Seems to involved in modulation of rDNA transcription. Preferentially binds GC-rich DNA in vitro and associates to GC-rich ribosomal RNA promoters. Involved in modulation of Toll-like receptor signaling. Required for the cAMP-dependent suppression of TNF-alpha in early stages of LPS-induced macrophage activation; the function probably implicates targeting of PKA to NFKB1 (By similarity).
Phosphorylated on tyrosine residues probably by SRC subfamily protein kinases; multiple phosphorylation is leading to dissociation from nuclear structures implicated in chromatin structural changes.
Nucleus. Nucleus matrix. Nucleus>Nucleolus. Cytoplasm.
Note: Associated with the nuclear matrix in interphase and redistributes mostly to chromatin at mitosis. However, mitotic chromatin localization has been questioned. Upon nuclear reassembly at the end of mitosis, is sequestered into the daughter nuclei where it re-acquires an interphase distribution. Localized to the nucleolus in interphase. Colocalizes with GJA1 at the nuclear membrane specifically during cell cycle G1/S phase.
Highly expressed in heart, liver, skeletal muscle, kidney and pancreas. Expressed in mature dendritic cells.
Belongs to the AKAP95 family.
References
Application: WB Species: Human Sample: A549 cells
Application: WB Species: Human Sample: A549 and Beas-2B cells
Restrictive clause
Affinity Biosciences tests all products strictly. Citations are provided as a resource for additional applications that have not been validated by Affinity Biosciences. Please choose the appropriate format for each application and consult Materials and Methods sections for additional details about the use of any product in these publications.
For Research Use Only.
Not for use in diagnostic or therapeutic procedures. Not for resale. Not for distribution without written consent. Affinity Biosciences will not be held responsible for patent infringement or other violations that may occur with the use of our products. Affinity Biosciences, Affinity Biosciences Logo and all other trademarks are the property of Affinity Biosciences LTD.